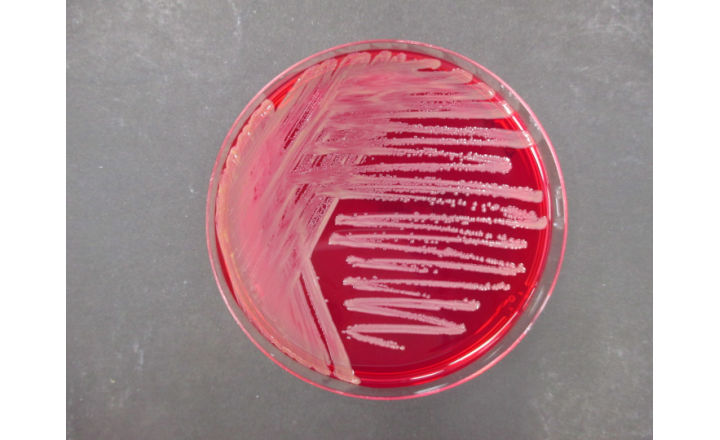

Shop
Description
USP <60> outlines the standardized method for the detection of Burkholderia cepacia complex (BCC), a group of objectionable microorganisms that pose a significant risk in non-sterile, water-based products. These organisms are of particular concern in pharmaceuticals, cosmetics, and personal care products due to their ability to survive in preserved systems and their association with opportunistic infections.
This test involves selective enrichment and isolation techniques designed to recover BCC organisms even in the presence of antimicrobial preservatives or competing microflora. The method includes:
- Sample preparation and neutralization of preservatives (if applicable)
- Selective enrichment for BCC organisms
- Plating on selective media
- Confirmation and identification of suspect colonies
USP <60> testing is commonly recommended for:
- Water-based cosmetics and personal care products
- Pharmaceutical non-sterile products (oral, topical, inhalation)
- Products intended for immunocompromised or sensitive populations
- Risk assessments and contamination investigations
At Pentyl Labs, USP <60> testing is performed through qualified partner laboratories with expertise in microbiological analysis. Final reports include confirmation of presence/absence of BCC and are suitable for regulatory, quality, and safety documentation.
Typical Turnaround Time: ~7 business days
Sample Requirement: ~50–100 g or mL
Result Format: Presence / Absence of BCC
Often paired with USP <61>/<62> Microbial Limits Testing and Preservative Efficacy Testing (USP <51>).